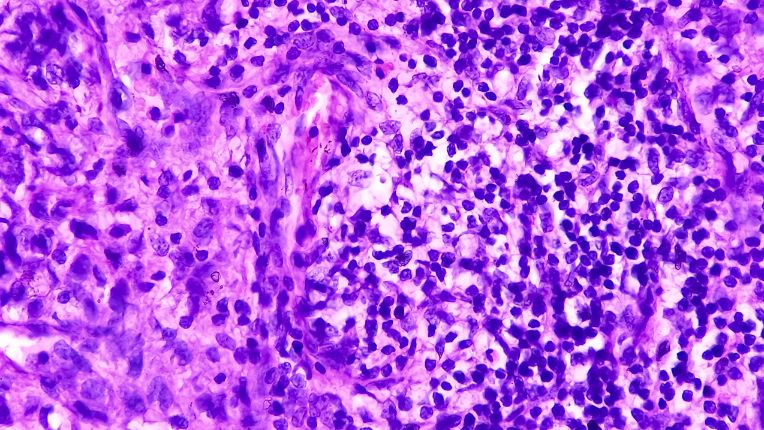
Opération de l’adénocarcinome par robot à Toulouse. Image au microscope d'un adénocarcinome de la prostate.

Opération de l’adénocarcinome par robot à Toulouse
Réservez votre rendez-vous avec un service équipé d’un robot dès aujourd’hui
Vous devez avoir une intervention chirurgicale oncologique à Toulouse (Haute-Garonne) ? Prenez rendez-vous avec nos spécialistes en chirurgie assistée par robot pour une prise en charge personnalisée.
Vous souhaitez consulter un spécialiste
Prendre rendez-vousVous allez être hospitalisé ?
Préparer mon séjourChambre particulière
Découvrir les services
A Toulouse, les avancées technologiques au service de la santé
Dans les cliniques ELSAN des dispositifs médicaux de haute technologie sont utilisés, comme le robot Da Vinci. Cette innovation a permis de faire progresser la chirurgie oncologique, facilitant notamment la pratique d’opérations en ambulatoire.
Le robot Da Vinci est une innovation médicale à la pointe de la technologie. Il présente plusieurs avantages :
-
dextérité ;
-
précision ;
-
intervention moins invasive ;
-
le patient récupère plus vite ;
-
les cicatrices sont plus petites ;
-
la cicatrisation est plus rapide…
Chirurgie par robot à Toulouse : une technologie au service des opérations en cancérologie
À Toulouse, la chirurgie des cancers, et notamment de certains adénocarcinomes, assistée par robot permet une prise en charge moins invasive et plus précise.
Une technologie à quatre bras motorisés
L’intervention se déroule sous le contrôle d’un-e chirurgien-ne qui pilote l’équipement à distance. Les gestes sont reproduits avec fidélité et sans tremblements involontaires, ce qui améliore la sécurité et la précision des actes réalisés.
Adénocarcinome : qu’est-ce que c’est ?
L'adénocarcinome est un type de cancer. Il s'agit d'une tumeur maligne qui se crée à partir d'un certain type de cellules, très répandues dans l'organisme : les cellules épithéliales glandulaires. L'épithélium est un tissu qui recouvre le corps et tapisse les organes dits creux : cela concerne, par exemple, l'appareil respiratoire, le système digestif, les organes reproducteurs et urinaires. Le cancer du sein, le cancer de l'estomac, le cancer de la prostate, le cancer du pancréas, le cancer colorectal sont souvent associés aux adénocarcinomes. L'adénocarcinome représente une forme spécifique de carcinome.
Adénocarcinome : traitements
Selon les formes de cancer, les types de tumeur, le stade du cancer, la réponse aux traitements, l'état de santé du ou de la patiente, plusieurs pistes de thérapies peuvent être envisageables en cas d'adénocarcinome. Les options sont :
-
chirurgie;
-
chimiothérapie;
-
radiothérapie;
-
thérapie ciblée;
-
immunothérapie.
Que recouvre la discipline de la cancérologie ?
L’oncologie ou cancérologie est la branche de la médecine qui traite les cancers. Elle repose sur plusieurs traitements médicaux :
-
la chimiothérapie ;
-
l’immunothérapie ;
-
les thérapies ciblées.
Quel professionnel de santé en cas d’adénocarcinome ?
La prise en charge des patients ou patientes qui sont atteintes d'un adénocarcinome est généralement pluridisciplinaire et inclut des oncologues, chirurgien-nes et autres spécialistes selon le ou les organes concernés.
Nos médecins
Clinique Ambroise-Paré à Toulouse
La clinique Ambroise-Paré à Toulouse (Haute-Garonne, 31) fait partie des meilleurs hôpitaux du département. Elle se distingue, en particulier, pour ses performances dans les spécialités médicales et chirurgicales. Elle est réputée notamment pour sa prise en charge du cancer de l’utérus.
Les dernières actualités sur le robot Da Vinci
Standard : 05 61 50 18 18
7h-20h la semaine
8h-20 le week-end
24h/7j les urgences
Visiteurs : 13h – 20h
Urgences obstétricales (24h/24) :05 61 50 16 94
Urgences (24h/24) : 05 61 50 15 15
